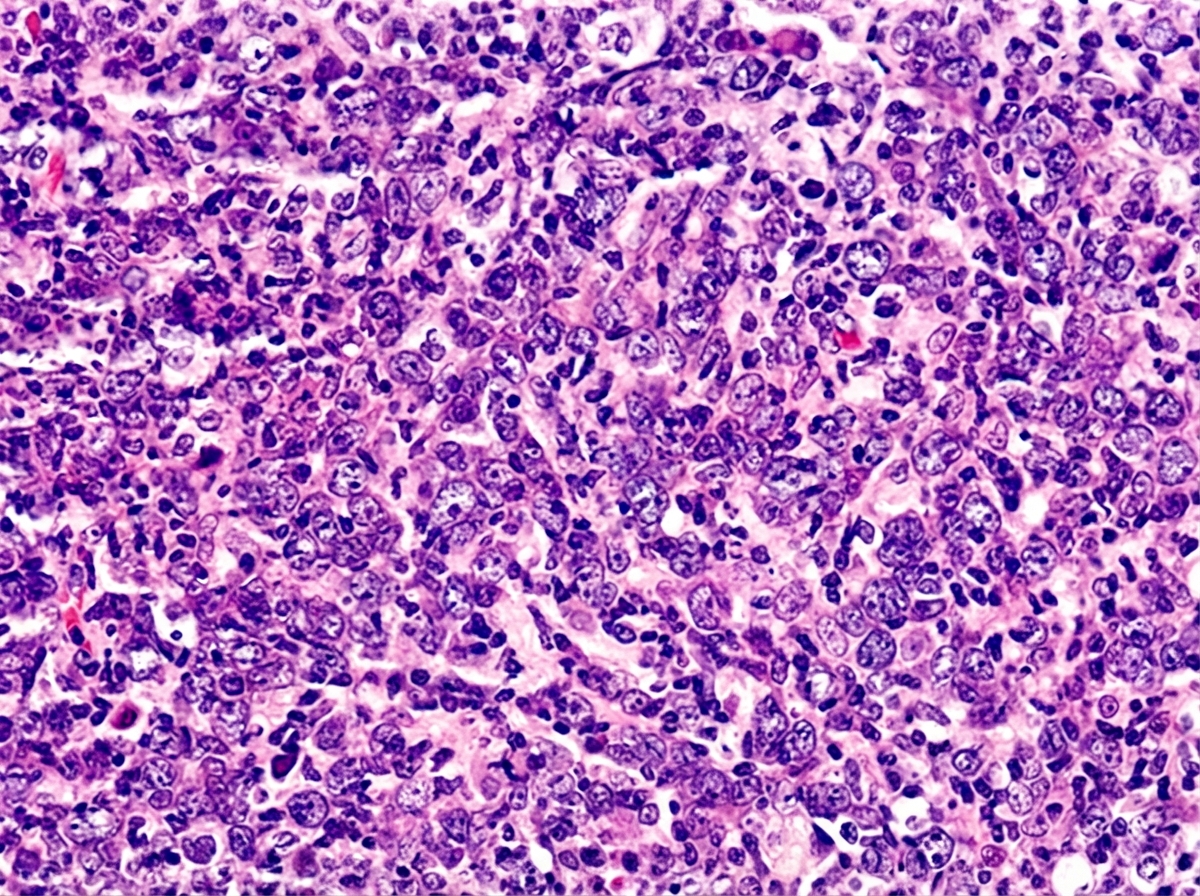
Image for question 78

An 8-year-old boy presents to his pediatrician accompanied by his father with a complaint of chronic cough. For the past 2 months he has been coughing up yellow, foul-smelling sputum. He has been treated at a local urgent care center for multiple episodes of otitis media, sinusitis, and bronchitis since 2 years of age. His family history is unremarkable. At the pediatrician's office, his temperature is 99.2°F (37.3°C), blood pressure is 110/84 mmHg, pulse is 95/min, and respirations are 20/min. Inspection shows a young boy who coughs occasionally during examination. Pulmonary exam demonstrates diffuse wheezing and crackles bilaterally. Mild clubbing is present on the fingers. The father has brought an electrocardiogram (ECG) from the patient’s last urgent care visit that shows pronounced right axis deviation. Which of the following is the most likely etiology of this patient’s condition?
A 3-year-old patient is brought to the emergency department by her mother due to inability to walk. The child has been limping recently and as of this morning, has refused to walk. Any attempts to make the child walk or bear weight result in crying. She was recently treated for impetigo and currently takes a vitamin D supplement. Physical exam is remarkable for an anxious appearing toddler with knee swelling, erythema, and limited range of motion due to pain. Her mother denies any recent trauma to the child's affected knee. Temperature is 103°F (39.4°C), pulse is 132/min, blood pressure is 90/50 mmHg, respirations are 18/min, and oxygen saturation is 99% on room air. Which of the following is the best initial step in management?
A 4-year-old boy is brought to the physician because of a 5-day history of sore throat and a painful swelling on the left side of his neck that has become progressively larger. He has had pain during swallowing and has refused to eat solid foods for the past 3 days. He immigrated to the United States one year ago from India. His immunization records are unavailable. His family keeps 2 cats as pets. He appears well. He is at the 60th percentile for height and 50th percentile for weight. His temperature is 37.7°C (99.9°F), pulse is 103/min, and blood pressure is 92/60 mm Hg. The oropharynx is erythematous; the tonsils are enlarged with exudates. There is a 3-cm warm, tender, nonfluctuant cervical lymph node on the left side of the neck. His hemoglobin is 12.6 g/dL, leukocyte count is 11,100/mm3, and platelet count is 180,000/mm3. In addition to obtaining a throat swab and culture, which of the following is the most appropriate next step in management?
A 2-year-old boy is brought to the physician because of the rash shown in the picture for 2 days. His mother says that the rash initially appeared on his face and neck. He has had fever, cough, and poor appetite for 5 days. The boy's family recently immigrated from Asia and is unable to provide his vaccination records. His temperature is 38.8°C (102.0°F), pulse is 105/min, and respiratory rate is 21/min. Physical examination shows fading of the rash over the face and neck without any desquamation. Examination of the oropharynx shows tiny rose-colored lesions on the soft palate. Enlarged tender lymph nodes are palpated in the suboccipital, postauricular and anterior cervical regions. The clinical presentation in this patient is most compatible with which of the following diseases?

A 4-year-old girl is brought to the emergency department by her parents with a sudden onset of breathlessness. She has been having similar episodes over the past few months with a progressive increase in frequency over the past week. They have noticed that the difficulty in breathing is more prominent during the day when she plays in the garden with her siblings. She gets better once she comes indoors. During the episodes, she complains of an inability to breathe and her parents say that she is gasping for breath. Sometimes they hear a noisy wheeze while she breathes. The breathlessness does not disrupt her sleep. On examination, she seems to be in distress with noticeable intercostal retractions. Auscultation reveals a slight expiratory wheeze. According to her history and physical findings, which of the following mechanisms is most likely responsible for this child’s difficulty in breathing?
A 3-year-old boy is brought to the physician because of a 3-day history of a pruritic skin rash on his chest. His mother says that he has no history of dermatological problems. He was born at term and has been healthy except for recurrent episodes of otitis media. His immunizations are up-to-date. He appears pale. His temperature is 37°C (98.6°F), pulse is 110/min, respirations are 26/min, and blood pressure is 102/62 mm Hg. Examination shows vesicles and flaccid bullae with thin brown crusts on the chest. Lateral traction of the surrounding skin leads to sloughing. Examination of the oral mucosa shows no abnormalities. Complete blood count is within the reference range. Which of the following is the most likely diagnosis?
An 8-year-old boy is brought to the emergency department 3 hours after having a 2-minute episode of violent, jerky movements of his right arm at school. He was sweating profusely during the episode and did not lose consciousness. He remembers having felt a chill down his spine before the episode. Following the episode, he experienced weakness in the right arm and was not able to lift it above his head for 2 hours. Three weeks ago, he had a sore throat that resolved with over-the-counter medication. He was born at term and his mother remembers him having an episode of jerky movements when he had a high-grade fever as a toddler. There is no family history of serious illness, although his father passed away in a motor vehicle accident approximately 1 year ago. His temperature is 37°C (98.6°F), pulse is 98/min, and blood pressure is 94/54 mm Hg. Physical and neurologic examinations show no abnormalities. A complete blood count and serum concentrations of glucose, electrolytes, calcium, and creatinine are within the reference range. Which of the following is the most likely diagnosis?
A 10-year-old boy is brought in by his mother with increasing abdominal pain for the past week. The patient’s mother says he has been almost constantly nauseous over that time. She denies any change in his bowel habits, fever, chills, sick contacts or recent travel. The patient has no significant past medical history and takes no medications. The patient is at the 90th percentile for height and weight and has been meeting all developmental milestones. The temperature is 36.8℃ (98.2℉). On physical examination, the patient’s abdomen is asymmetrically distended. Bowel sounds are normoactive. No lymphadenopathy is noted. A cardiopulmonary examination is unremarkable. Palpation of the right flank and right iliac fossa reveals a 10 × 10 cm firm mass which is immobile and tender. The laboratory findings are significant for the following: Hemoglobin 10 g/dL Mean corpuscular volume 88 μm3 Leukocyte count 8,000/mm3 Platelet count 150,000/mm3 Serum creatinine 1.1 mg/dL Serum lactate dehydrogenase (LDH) 1,000 U/L An ultrasound-guided needle biopsy of the flank mass was performed, and the histopathologic findings are shown in the exhibit (see image). Which of the following is the most likely diagnosis in this patient?
A 7-year-old girl is brought to the pediatrician by her parents for red papules over her left thigh and swelling in the right axilla for the past few days. Her parents say that she had a cat bite on her left thigh 2 weeks ago. Her temperature is 38.6°C (101.4°F), pulse is 90/min, and respirations are 22/min. On her physical examination, hepatosplenomegaly is present with a healing area of erythema on her left thigh. Her laboratory studies show: Hemoglobin 12.9 gm/dL Leukocyte count 9,300/mm3 Platelet count 167,000/mm3 ESR 12 mm/hr Which of the following is the most appropriate next step in management?
A 7-year-old boy is brought into the emergency department after he was found at home by his mother possibly drinking a drain cleaning solution from under the sink. The child consumed an unknown amount and appears generally well. The child has an unremarkable past medical history and is not currently taking any medications. Physical exam reveals a normal cardiopulmonary and abdominal exam. Neurological exam is within normal limits and the patient is cooperative and scared. The parents state that the ingestion happened less than an hour ago. Which of the following is the best next step in management?
Common childhood exanthems
Practice Questions
Pediatric respiratory infections
Practice Questions
Pediatric gastrointestinal infections
Practice Questions
Urinary tract infections in children
Practice Questions
Bone and joint infections
Practice Questions
Central nervous system infections
Practice Questions
Pediatric tuberculosis
Practice Questions
Pediatric HIV
Practice Questions
Recurrent infections evaluation
Practice Questions
Fever of unknown origin approach
Practice Questions
Emerging infectious diseases in children
Practice Questions
Post-infectious immune complications
Practice Questions
Antimicrobial resistance in pediatrics
Practice Questions
Get full access to all questions, explanations, and performance tracking.
Scan to download app